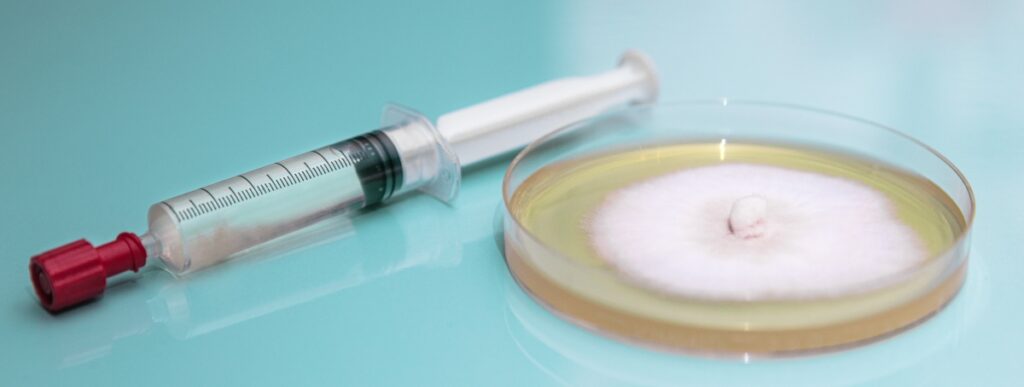
The Fascinating World of Mushroom Spore Syringes

Mushrooms, with their diverse species and mystical properties, have been the subject of intrigue for millennia. Beyond their culinary and medicinal uses, their reproductive process is equally captivating. At the heart of this process are spores – microscopic cells that give life to a new mushroom. And to study, cultivate, or simply appreciate these spores, many enthusiasts are turning to mushroom spore syringes.
Unlike seeds in plants, spores don’t contain embryonic plants but are equipped to start the mushroom growth process under the right conditions. These tiny marvels are collected and suspended in a sterile solution, and this concoction is what is known as a spore syringe.
Advantages of Using Spore Syringes
The use of mushroom spore syringes offers several advantages for mycologists, hobbyists, and researchers. First and foremost, they provide a sterile environment for the spores, reducing the risk of contamination which can be detrimental to mushroom cultivation. This sterility ensures that the subsequent mushroom growth remains true to its species without the interference of foreign contaminants.
Additionally, the syringes allow for precise application. Whether you’re inoculating substrates or studying them under a microscope, the ability to control the amount and location of the spore deposit is invaluable.
The Ethical and Legal Considerations
While these tools open up a world of possibilities for study and cultivation, it’s crucial to approach this area with knowledge and responsibility. Certain mushroom spores, especially those of psychedelic varieties, are subject to legal restrictions in many regions. Thus, it’s imperative for anyone interested in this field to be well-versed in their local regulations and always prioritize ethical considerations.
Subheading: From Syringe to Sprout
For those who wish to embark on the journey of mushroom cultivation using spore syringes, the process can be deeply rewarding. After selecting a suitable substrate, the spores are introduced through inoculation. With the right moisture, temperature, and environment, these spores will germinate, leading to the growth of mycelium – the vegetative part of the fungus. Over time, with care and patience, this mycelium network will yield a flourishing mushroom crop.
A Conduit to Nature’s Secrets
Beyond cultivation, these instruments serve as a window into the intricate world of fungi. For researchers, they offer a chance to delve deeper into the genetics, biology, and potential applications of mushrooms. The revelations from such studies have far-reaching implications, from understanding ecosystems to discovering novel medical treatments.
Concluding Thoughts
The world of fungi is vast and mysterious. And in this realm, mushroom spore syringes play a pivotal role. They are not just tools for cultivation but are instrumental in advancing our understanding of the fungal kingdom. As we continue to explore and respect this domain, the potential for new discoveries and applications seems boundless.